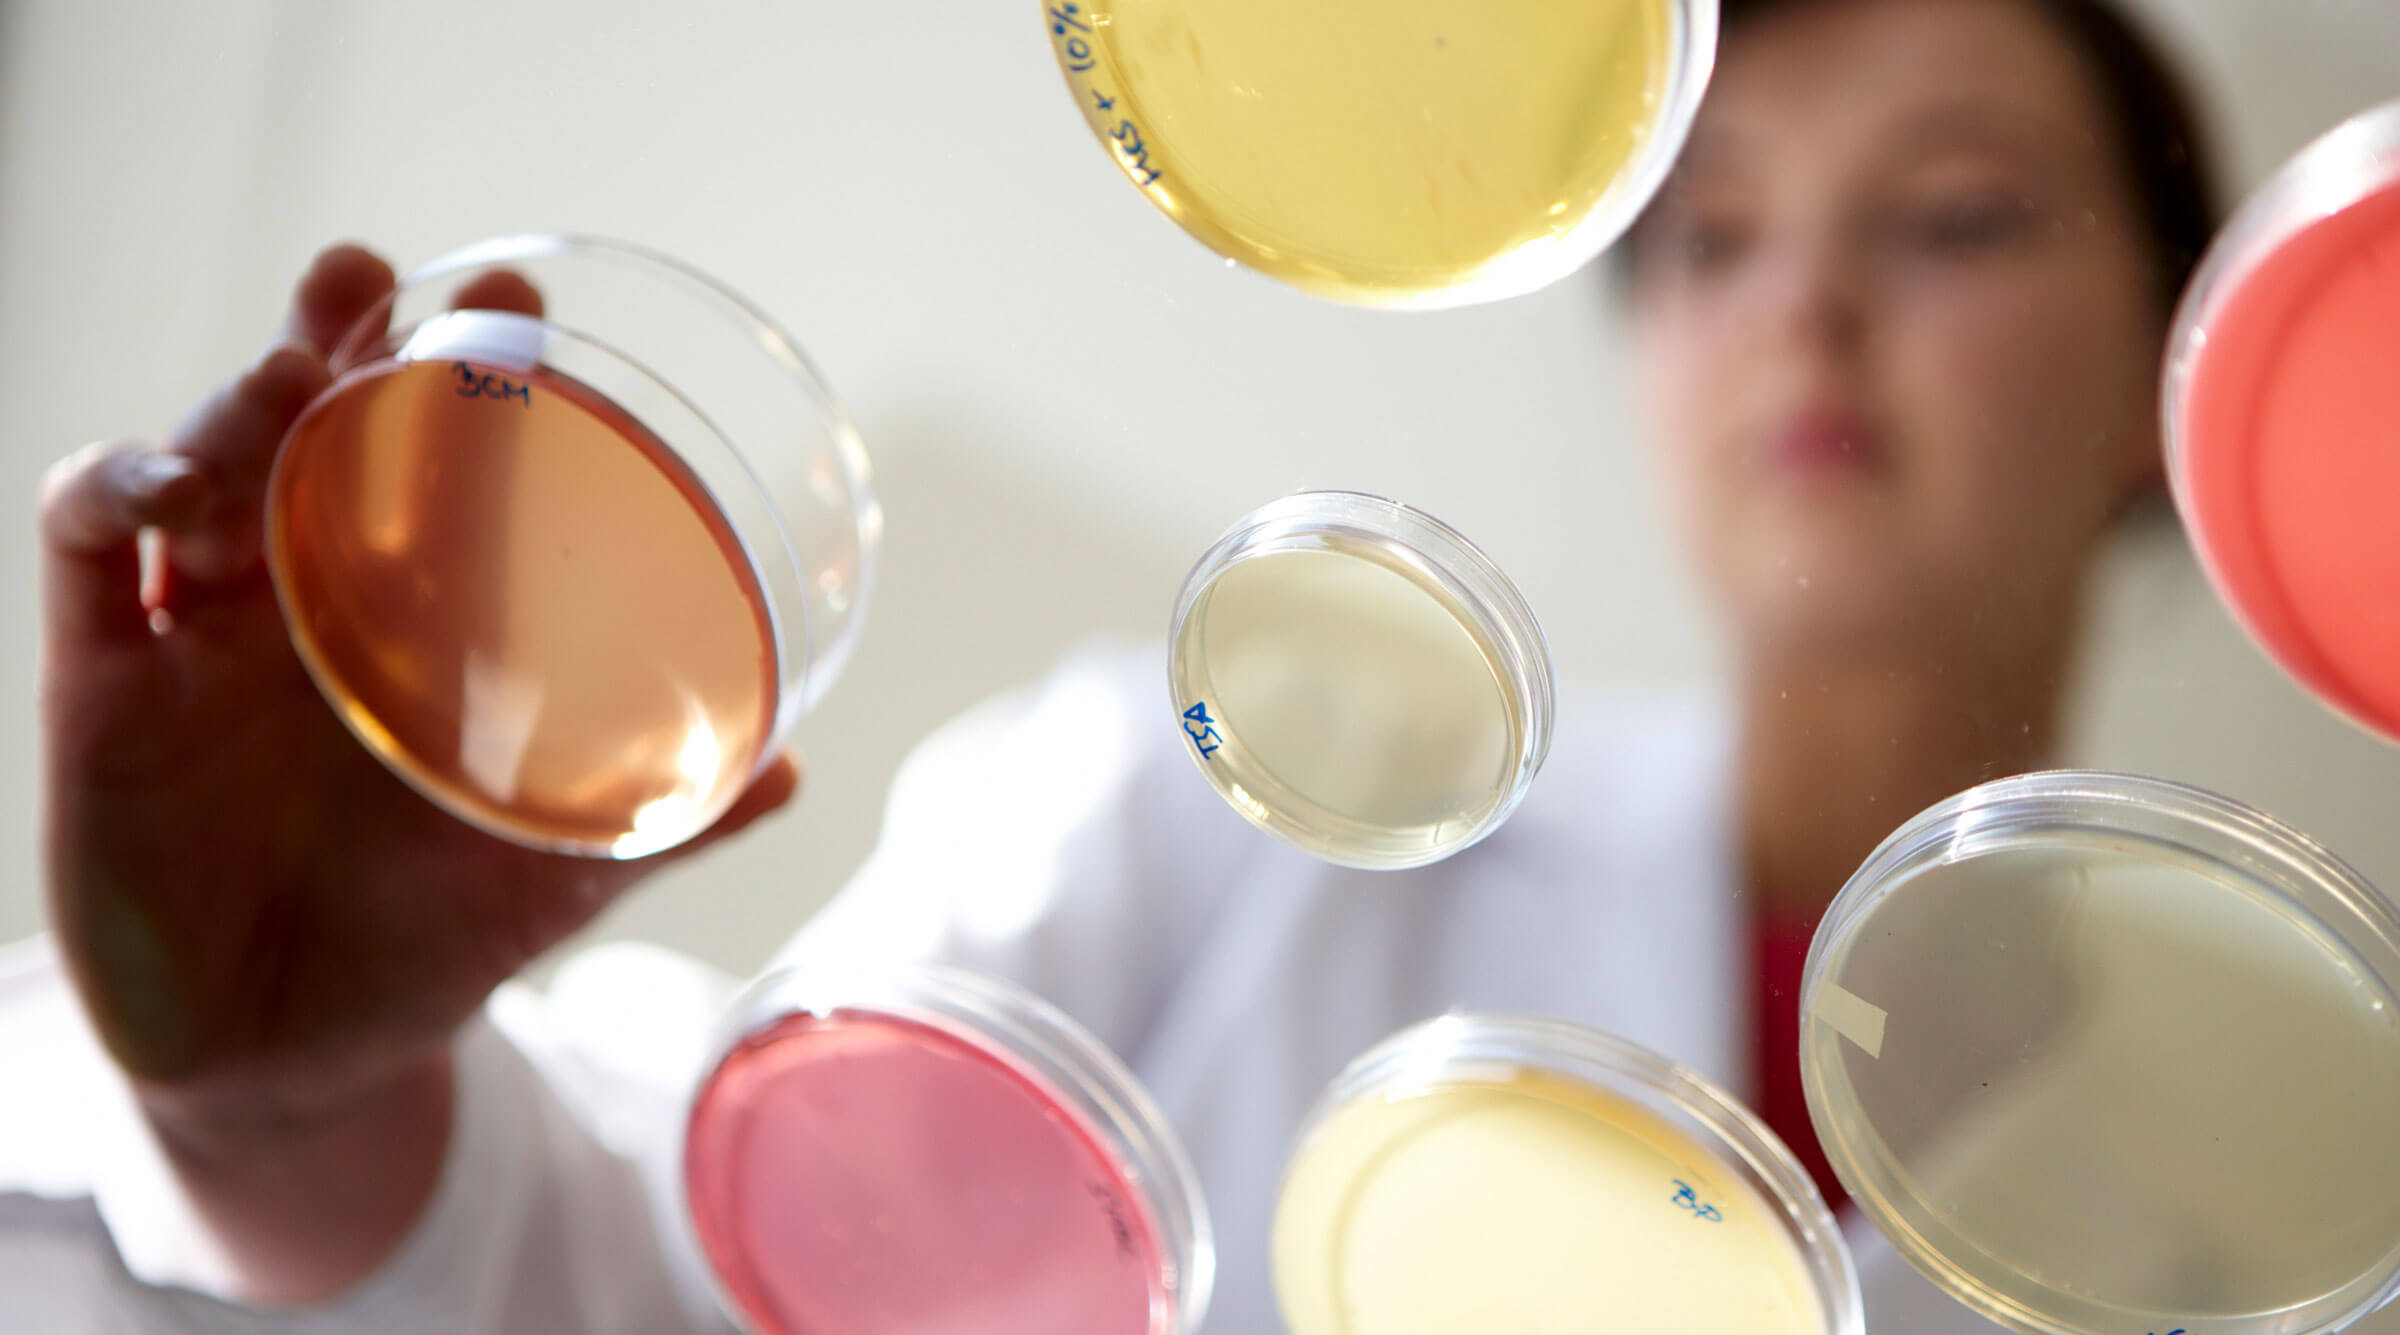
analisis en laboratorio

Investigación y desarrollo de pesca sostenible
La innovación, el desarrollo y la transferencia tecnológica que realizamos responden a la necesidad de los sectores de la economía del mar y del litoral de asegurar una utilización eficiente de los recursos que garanticen la sostenibilidad ambiental, económica y social de su actividad.

Nuestra actividad se centra en tres áreas de investigación:
Índice de contenidos
Gestión pesquera
En AZTI trabajamos, en colaboración con los principales centros de investigación pesquera europeos y mundiales, para sentar las bases científicas para la sostenibilidad del medio marino y de sus recursos pesqueros.
Contribuimos eficaz y equitativamente al conocimiento y a la evaluación integral de las principales especies explotadas por las flotas del País Vasco operando en cualquiera de los mares y océanos del mundo.
Nuestra labor de investigación la realizamos en el marco de organismos internacionales tales como ICCAT, IOTC, ICES/CIEM, NAFO, STEFC, etc., en los que personal investigador de AZTI participa activamente.
Participamos activamente en la elaboración del consejo científico de gestión en el que basar la explotación sostenible de los recursos y de la actividad pesquera, de modo que las respectivas administraciones establezcan las decisiones y medidas de gestión en base al conocimiento científico del estado de los recursos y de la economía de las flotas.
Nos centramos en tres líneas de trabajo:
- Observación y datos
- Evaluación y gestión integrada de recursos vivos
- Aproximación ecosistémica a la gestión
Tecnologías pesqueras
Eficiencia del sector pesquero en la explotación sostenible de los recursos del mar
En AZTI investigamos alternativas tecnológicas para aportar soluciones que permitan minimizar los impactos de la pesca en el medio marino, mejorar la operativa del trabajo a bordo de los buques de pesca, y en particular la seguridad y el confort laboral del trabajo en el mar. Lo hacemos, en estrecha colaboración con el sector pesquero, a través de proyectos de investigación centrados en tres campos de actividad:
- Reducción del impacto ambiental de la pesca extractiva
- Operativas para una pesca sostenible y su optimización
- Eficiencia energética en el ámbito marítimo-pesquero
Acuicultura
En AZTI buscamos alternativas para cubrir la creciente demanda de pescado.
Generamos soluciones tecnológicas orientadas al desarrollo sostenible (económico, social y medioambiental) de la acuicultura marina.